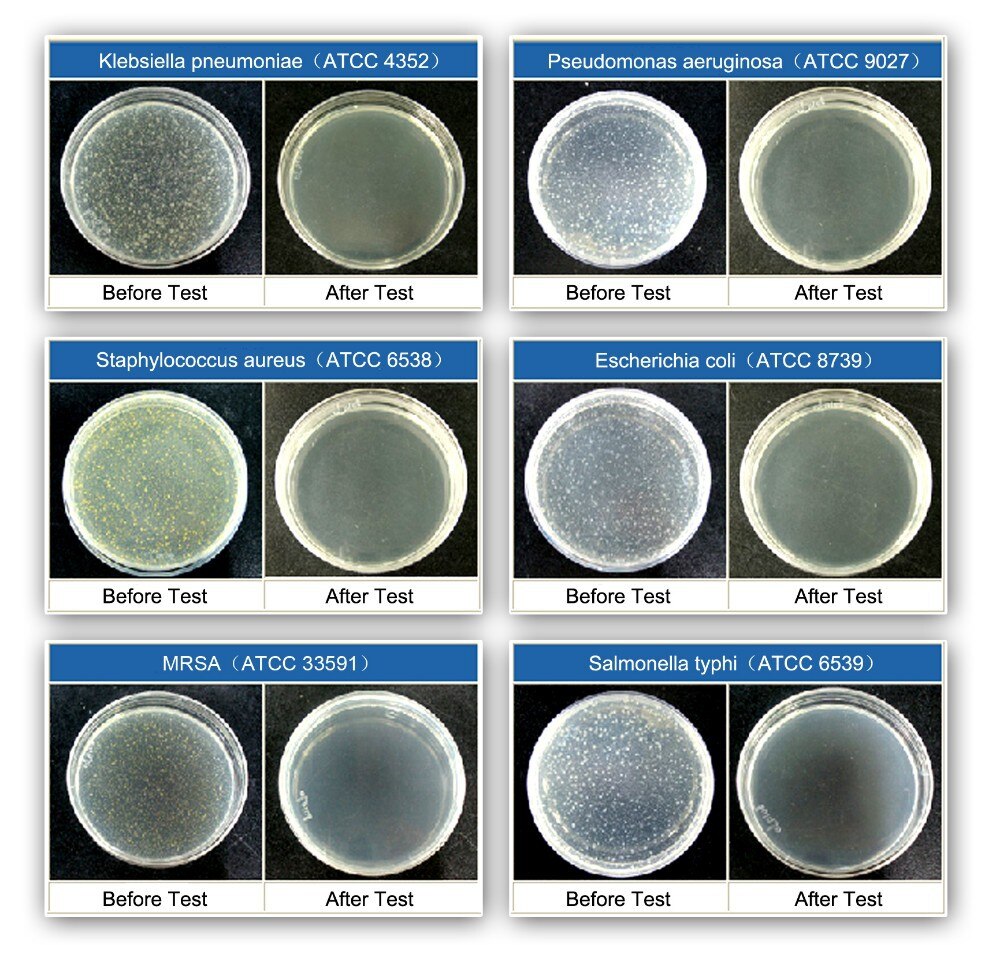

Désinfectez votre maison, école, bureau, jouets pour enfants, bols pour animaux de compagnie, sans avoir besoin de produits chimiques avec la toute nouvelle baguette désinfectante antibactérienne ultra-violette!
Il est révolu le temps où vous, vos enfants, votre conjoint, un ami ou un animal de compagnie tombiez malades en raison d’allergies, la baguette désinfectante antibactérienne ultra-violette désinfecte instantanément toutes les surfaces de votre maison, éliminant les spores, les acariens, les moisissures, les bactéries, ETC à une simple pression sur un interrupteur.

Gardez les matelas exempts d’acariens et de germes. La baguette désinfectante anti-bactérienne UV tue 99,78% de toutes les bactéries, germes, virus, acariens, etc. Les acariens vivent et se nourrissent dans tous nos lits et meubles, et s’ils ne prennent pas soin de nous, cela peut être un problème pour notre santé à long terme, propager des maladies et des maladies à nos enfants et à nos familles.

Maintenant, d’un simple clic sur un bouton, vous pouvez éliminer en toute sécurité ces nuisibles nuisibles dangereux de votre maison, sans exposer les membres de votre famille à des produits chimiques dangereux. Fini les bactéries, virus, germes, acariens, moisissures, etc. Tenez simplement la baguette désinfectante anti-bactérienne UV près des endroits infectés et, comme par magie, vous êtes exempt de bactéries, virus, germes, acariens, moisissures, etc.

Caractéristiques:
- Taille portable et poids léger, très approprié pour les voyages d’affaires, les voyages, l’hôtel, la maison et le bureau.
- Affichage de l’heure sur l’écran LED, mode de fermeture automatique du compte à rebours du temps germicide. Quatre réglages d’heure: 5 minutes / 15 minutes / 30 minutes / mode série.
- Interrupteur de sécurité intégré: à l’état de fonctionnement, la lumière ultraviolette s’éteint automatiquement lors de la rotation de la tige de stérilisation vers le haut. Lorsque la lampe de la tige de stérilisation est tournée vers le bas, cela fonctionne.
- Utilisez la lumière ultraviolette pour tuer les bactéries, les virus et les moisissures des produits ménagers. Élimine les odeurs, les bactéries et la poussière qui causent la rate, la pneumonie, l’asthme et les allergies.
- Utilisé dans la vie quotidienne, baguettes, cuillères, plats, téléphones, bureaux, toilettes, lieux publics, voitures, etc.
- Utilisé régulièrement sur les surfaces et les objets, aidera à garder votre maison exempte de germes et en sécurité sans risque de contamination chimique.

Specifications:
• Taille: L363 x L46 x H37 mm.
• Poids: 200g.
• Lampe UV-C: Lampe CC 3W.
• Longueur d’onde UV: UV-C (253,7 nm).
• Batterie: batterie au lithium-ion rechargeable (3,7 V 1500 mA / h).
• Alimentation: sortie: 5.0V 1A / entrée: AC100 ~ 240V 50/60 Hz.
• Certificat (s): CE, RoHS, FDA.
• Couleur bleu

Questions et réponses:
Q: Quelle est cette lumière ultraviolette utilisée à l’intérieur du stérilisateur ultraviolet portable?
R: C’est ce qu’on appelle la lumière ultraviolette (UV-C). Les UV-B sont les plus courants. Les UV-C ont une fréquence plus élevée de la lumière UV qui peut tuer les germes. Il fait partie du spectre de la lumière ultraviolette.
Q: Les UV-C sont-ils nocifs?
R: Seule une exposition prolongée (c.-à-d. 8 heures ou plus) à la lumière UV-C sera nocive pour l’homme.
Q: Comment les UV-C tuent les germes?
R: La lumière UV-C est très efficace pour pénétrer les germes à parois minces comme les virus et les bactéries. La lumière modifie la structure génétique du germe et ils meurent.
Pourquoi nous?
Chez shopibest nous comprenons que l’achat en ligne peut être décourageant, c’est pourquoi nous offrons une garantie de remboursement à 100%. Si vous n’êtes pas satisfait par notre produit, envoyez nous un mail et bénéficiez d’un remboursement intégral.



















